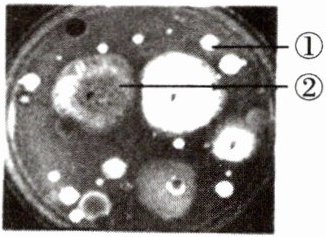

第112页
- 第1页
- 第2页
- 第3页
- 第4页
- 第5页
- 第6页
- 第7页
- 第8页
- 第9页
- 第10页
- 第11页
- 第12页
- 第13页
- 第14页
- 第15页
- 第16页
- 第17页
- 第18页
- 第19页
- 第20页
- 第21页
- 第22页
- 第23页
- 第24页
- 第25页
- 第26页
- 第27页
- 第28页
- 第29页
- 第30页
- 第31页
- 第32页
- 第33页
- 第34页
- 第35页
- 第36页
- 第37页
- 第38页
- 第39页
- 第40页
- 第41页
- 第42页
- 第43页
- 第44页
- 第45页
- 第46页
- 第47页
- 第48页
- 第49页
- 第50页
- 第51页
- 第52页
- 第53页
- 第54页
- 第55页
- 第56页
- 第57页
- 第58页
- 第59页
- 第60页
- 第61页
- 第62页
- 第63页
- 第64页
- 第65页
- 第66页
- 第67页
- 第68页
- 第69页
- 第70页
- 第71页
- 第72页
- 第73页
- 第74页
- 第75页
- 第76页
- 第77页
- 第78页
- 第79页
- 第80页
- 第81页
- 第82页
- 第83页
- 第84页
- 第85页
- 第86页
- 第87页
- 第88页
- 第89页
- 第90页
- 第91页
- 第92页
- 第93页
- 第94页
- 第95页
- 第96页
- 第97页
- 第98页
- 第99页
- 第100页
- 第101页
- 第102页
- 第103页
- 第104页
- 第105页
- 第106页
- 第107页
- 第108页
- 第109页
- 第110页
- 第111页
- 第112页
- 第113页
微生物的分布

- 菌落:由一个或多个细菌或真菌繁殖后形成的肉眼可见的
- 区分菌落
(1)细菌:菌落比较
(2)真菌:菌落比较
细菌和真菌的分布
- 培养细菌和真菌的一般方法:①配制
- 分布特点:
- 生存条件:需要

- 菌落:由一个或多个细菌或真菌繁殖后形成的肉眼可见的
集合体
,称为菌落- 区分菌落
(1)细菌:菌落比较
小
,表面或光滑黏稠
,或粗糙干燥
,颜色可呈白色
等多种颜色(2)真菌:菌落比较
大
,霉菌形成的菌落常呈绒毛
状、絮
状或蜘蛛网
状,有时还呈现红、褐、绿、黑、黄
等不同的颜色细菌和真菌的分布
- 培养细菌和真菌的一般方法:①配制
培养基
,②对材料和用具进行高温灭菌
,③接种
,④恒温培养- 分布特点:
广泛
分布- 生存条件:需要
水分
、适宜的温度
和有机物
等,有些细菌必须在无氧
条件下生存
答案:
集合体;小;光滑黏稠;粗糙干燥;白色;大;绒毛;絮;蜘蛛网;红、褐、绿、黑、黄;培养基;高温灭菌;接种;广泛;水分;适宜的温度;有机物;无氧
例1 在培养细菌和真菌的实验中,培养基上的菌落①和②的生长情况如下图所示。下列有关叙述正确的是 (

A.图中①就是一个细菌细胞
B.图中①的表面呈绒毛状或絮状
C.图中②为某种真菌的子细胞群体
D.图中②表面光滑黏稠,一般无颜色
【思路剖析】菌落是由一个或多个细菌或真菌繁殖后形成的肉眼可见的子细胞群体,故A错误。细菌的菌落较小,表面或光滑黏稠,或粗糙干燥,图中①为某种细菌的菌落,故B错误。真菌的菌落较大,其中霉菌的菌落常呈绒毛状、絮状或蜘蛛网状。真菌菌落可呈现白、红、褐、绿、黑、黄等不同的颜色。因此图中②是真菌菌落,故C正确,D错误。
【答案】C
C
)
A.图中①就是一个细菌细胞
B.图中①的表面呈绒毛状或絮状
C.图中②为某种真菌的子细胞群体
D.图中②表面光滑黏稠,一般无颜色
【思路剖析】菌落是由一个或多个细菌或真菌繁殖后形成的肉眼可见的子细胞群体,故A错误。细菌的菌落较小,表面或光滑黏稠,或粗糙干燥,图中①为某种细菌的菌落,故B错误。真菌的菌落较大,其中霉菌的菌落常呈绒毛状、絮状或蜘蛛网状。真菌菌落可呈现白、红、褐、绿、黑、黄等不同的颜色。因此图中②是真菌菌落,故C正确,D错误。
【答案】C
答案:
C
查看更多完整答案,请扫码查看


